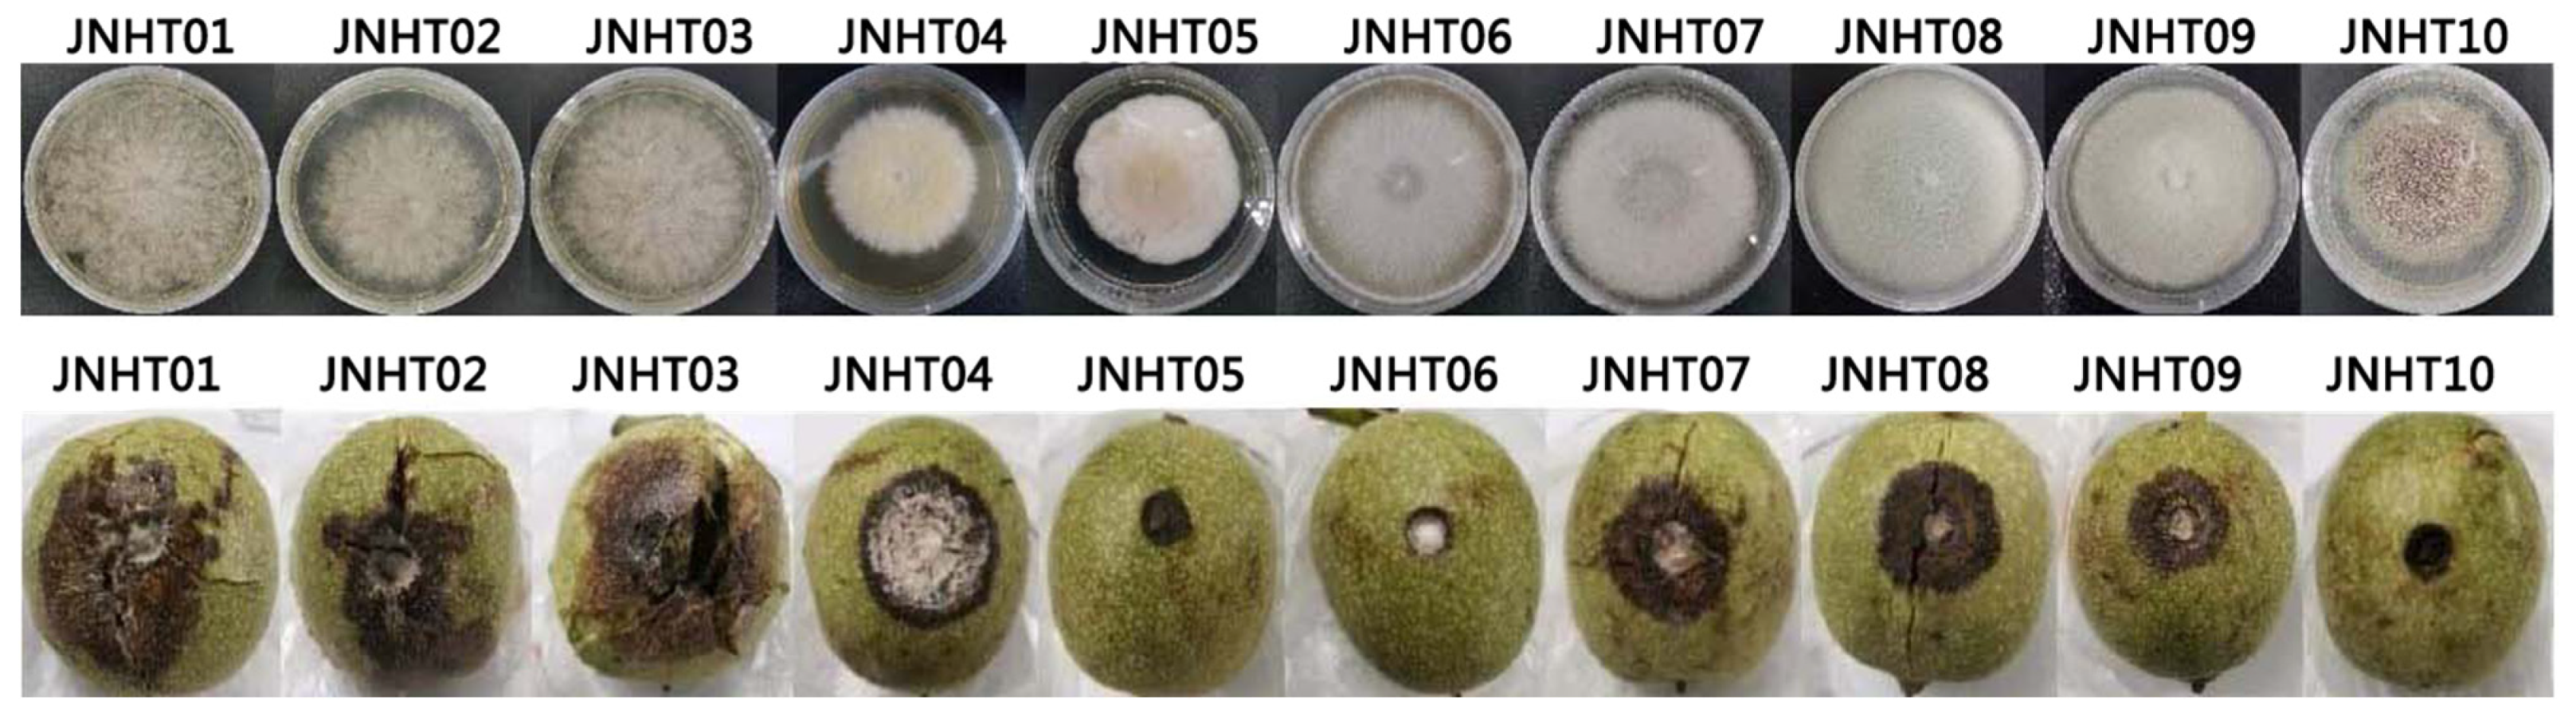

Exploring the Efficacy of Biocontrol Microbes against the Fungal Pathogen Botryosphaeria dothidea JNHT01 Isolated from Fresh Walnut Fruit
Abstract
1. Introduction
2. Materials and Methods
2.1. Fruit Sample and Antagonistic Agent
2.2. Isolation and Purification of Pathogenic Fungi
2.3. Identification of Pathogenic Fungi
2.3.1. Morphological Identification
2.3.2. Molecular Identification
2.4. Characterization of the Fungal Pathogen
2.4.1. Pathogenicity of the Fungal Pathogen on Walnuts
2.4.2. Growth Characteristics of Pathogenic Fungi
2.5. Determination of Antifungal Potential of Biocontrol Agents
2.5.1. Preparation of Cell-Free Supernatants
2.5.2. Antifungal Concentration of Biocontrol Agents
2.5.3. In Vitro Antagonistic Activity Determination
2.6. Data Statistics and Analysis
3. Results
4. Discussion
5. Conclusions
Author Contributions
Funding
Data Availability Statement
Conflicts of Interest
References
- Food and Agriculture Organization. Save Food: The Global Initiative on Food Loss and Waste Reduction; Food and Agriculture Organization: Rome, Italy, 2011; Available online: https://www.fao.org/ (accessed on 6 October 2022).
- Yun, Z.; Gao, H.; Jiang, Y. Insights into metabolomics in quality attributes of postharvest fruit. Curr. Opin. Food Sci. 2022, 45, 100836. [Google Scholar] [CrossRef]
- Matrose, N.A.; Obikeze, K.; Belay, Z.A.; Caleb, O.J. Plant extracts and other natural compounds as alternatives for post-harvest management of fruit fungal pathogens: A review. Food Biosci. 2021, 41, 100840. [Google Scholar] [CrossRef]
- Chen, T.; Ji, D.; Zhang, Z.; Li, B.; Qin, G.; Tian, S. Advances and strategies for controlling the quality and safety of postharvest fruit. Engineering 2021, 7, 1177–1184. [Google Scholar] [CrossRef]
- Adkison, C.; Richmond, K.; Lingga, N.; Bikoba, V.; Mitcham, E. Optimizing walnut storage conditions: Effects of relative humidity temperature and shelling on quality after storage. HortScience 2021, 56, 1244–1250. [Google Scholar]
- Cahoon, D.; Shertukde, S.P.; Avendano, E.E.; Tanprasertsuk, J.; Scott, T.M.; Johnson, E.J.; Chung, M.; Nirmala, N. Walnut intake cognitive outcomes and risk factors: A systematic review and meta-analysis. Ann. Med. 2021, 53, 972–998. [Google Scholar]
- Ma, Y.; Li, P.; Watkins, C.B.; Ye, N.; Jing, N.; Ma, H.; Zhang, T. Chlorine dioxide and sodium diacetate treatments in controlled atmospheres retard mold incidence and maintain quality of fresh walnuts during cold storage. Postharvest Biol. Tec. 2020, 161, 111063. [Google Scholar]
- Zhu, Y.; Yin, Y.; Qu, W.; Yang, K. Occurrence and spread of the pathogens on walnut (Juglans regia) in Shandong Province, China. Acta Hortic. 2014, 1050, 347–351. [Google Scholar] [CrossRef]
- Wang, H.; Fu, L.; Meng, J.; Ding, R.; Wang, Y.; Wang, X.; Han, C.; Li, L.; Zhu, C. Antagonistic activity and biocontrol effects of Streptomyces sp. CX3 cell-free supernatant against blueberry canker caused by Botryosphaeria dothidea. Crop Prot. 2022, 162, 106072. [Google Scholar]
- Xin, L.; Zhang, R.; Wang, X.; Liu, X.; Wang, Y.; Qi, P.; Wang, L.; Wu, S.; Chen, X. Extracellular and intracellular infection of Botryosphaeria dothidea and resistance mechanism in apple cells. Hortic. Plant J. 2022, in press. [Google Scholar]
- Yang, R.; Wang, J.; Cai, Z.; Shen, Y.; Gan, Z.; Duan, B.; Yuan, J.; Huang, T.; Zhang, W.; Du, H. Transcriptome profiling to elucidate mechanisms of the enhancement of the resistance to Botryosphaeria dothidea by nitric oxide in postharvest kiwifruit during storage. LWT Food Sci. Technol. 2022, 159, 113187. [Google Scholar]
- Yildiz, A.; Benlioglu, S.; Benlioglu, K.; Korkom, Y. Occurrence of twig blight and branch dieback of walnut caused by Botryosphaeriaceae species in Turkey. J. Plant Dis. Prot. 2022, 129, 687–693. [Google Scholar] [CrossRef]
- Lee, D.H.; Cho, S.E.; Oh, J.Y.; Lee, S.H. Molecular Confirmation of the occurrence of Botryosphaeria dothidea responsible for branch dieback and canker on Juglans sinensis in South Korea. J. For. Environ. Sci. 2020, 36, 326–327. [Google Scholar]
- Hattomil, Y.; And, Y.; Nakashimai, C. Phylogenetic study of the tree parasitic Botryosphaeria isolates in Japan. Nippon Kingakukai Kaiho 2021, 62, 1–11. [Google Scholar]
- Luo, Y.; Niederholzer, F.J.A.; Lightle, D.M.; Felts, D.; Lake, J.; Michailides, T.J. Limited Evidence for accumulation of latent infections of canker-causing pathogens in shoots of stone fruit and nut crops in California. Phytopathology 2021, 111, 1963–1971. [Google Scholar] [PubMed]
- Yun, Y.S.; Bae, S.J.; Park, S.H. Inactivation of foodborne pathogens on inshell walnuts by UV-C radiation. J. Food Prot. 2022, 85, 1172–1176. [Google Scholar]
- Grosso, A.L.; Asensio, C.M.; Grosso, N.R.; Nepote, V. Increase of walnuts’ shelf life using a walnut flour protein-based edible coating. LWT Food Sci. Technol. 2020, 118, 108712. [Google Scholar]
- Berta, M.; Molnár, I.; Zentai, Á.; Kecskeméti, A.; Kerekes, E.B.; Nacsa-Farkas, E.; Gömöri, C.; Vidács, A.; Kocsubé, S.; Bencsik, O. Preservation effect of cinnamon and clove essential oil vapors on shelled walnut. Acta Biol. Szeged. 2018, 62, 141–145. [Google Scholar] [CrossRef]
- Sare, A.R.; Jijakli, M.H.; Massart, S. Microbial ecology to support integrative efficacy improvement of biocontrol agents for postharvest diseases management. Postharvest Biol. Tec. 2021, 179, 111572. [Google Scholar]
- Qin, X.; Xiao, H.; Cheng, X.; Zhou, H.; Si, L. Hanseniaspora uvarum prolongs shelf life of strawberry via volatile production. Food Microbiol. 2017, 63, 205–212. [Google Scholar]
- Tuitte, J. Plant Pathological Methods, Fungi and Bacteria; Burgess Publishing Company: Minneapolis, MN, USA, 1969; p. 239. [Google Scholar]
- Cai, J.; Chen, J.; Lu, G.; Zhao, Y.; Tian, S.; Qin, G. Control of brown rot on jujube and peach fruits by trisodium phosphate. Postharvest Biol. Tec. 2015, 99, 93–98. [Google Scholar]
- Xiong, Z.Q.; Tu, X.R.; Wei, S.J.; Huang, L.; Li, X.H.; Lu, H.; Tu, G.Q. The mechanism of antifungal action of a new polyene macrolide antibiotic antifungalmycin 702 from Streptomyces padanus JAU4234 on the rice sheath blight pathogen Rhizoctonia solani. PLoS ONE 2013, 8, e73884. [Google Scholar] [CrossRef] [PubMed]
- Li, X.; Lin, J.; Gao, Y.; Han, W.; Chen, D. Antioxidant activity and mechanism of Rhizoma Cimicifugae. Chem. Cent. J. 2012, 6, 140. [Google Scholar]
- Zhang, S.; Zheng, Q.; Xu, B.; Liu, J. Identification of the fungal pathogens of postharvest disease on peach fruits and the control mechanisms of Bacillus subtilis jk-14. Toxins 2019, 11, 322. [Google Scholar] [CrossRef]
- Pinter, C.; Fischl, G.; Kadlicsko, S.; Danko, J.; Gara, M.; Mako, S. Pathogens of walnut in Hungary. Acta Phytopathol. Et Entomol. Hung. 2001, 36, 269–273. [Google Scholar] [CrossRef]
- Nkwonta, C.G.; Medina, A.; del Carmen, A.M.; Terry, L.A. Impact of postharvest processing on the fungal population contaminating African walnut shells (Tetracarpidium conophorum Mull. Arg) at different maturity stages and potential mycotoxigenic implications. Int. J. Food Microbiol. 2015, 194, 15–20. [Google Scholar] [CrossRef]
- Wei, L.; Fu, H.; Lin, M.; Dang, H.; Zhao, Y.; Xu, Y.; Zhang, B. Identification of dominant fungal contamination of walnut in Northwestern China and effects of storage conditions on walnut kernels. Sci. Hortic. 2020, 264, 109141. [Google Scholar]
- Tang, W.; Ding, Z.; Zhou, Z.; Wang, Y.; Guo, L. Phylogenetic and pathogenic analyses show that the causal agent of apple ring rot in China is Botryosphaeria dothidea. Plant Dis. 2012, 96, 486–496. [Google Scholar] [PubMed]
- Pang, L.; Xia, B.; Liu, X.B.; Yi, Y.J.; Jiang, L.W.; Chen, C.; Li, P.; Zhang, M.; Deng, X.B.; Wang, R.C. Improvement of antifungal activity of a culture filtrate of endophytic Bacillus amyloliquefaciens isolated from kiwifruit and its effect on postharvest quality of kiwifruit. J. Food Biochem. 2020, 45, e13551. [Google Scholar]
- Wang, D.; Zhang, Y.B.; Chang, J.; Meng, K.; Shu, J.P.; Zhai, F.Y. First report of fruit black spot of pecan (Carya illinoensis) caused by Botryosphaeria dothidea in China. Plant Dis. 2020, 105, 2731. [Google Scholar]
- Li, G.; Liu, F.; Li, J.; Liu, Q.; Chen, S. Characterization of Botryosphaeria dothidea and Lasiodiplodia pseudotheobromae from English walnut in China. J. Phytopathol. 2016, 164, 348–353. [Google Scholar] [CrossRef]
- Li, J.; Fu, S.; Fan, G.; Li, D.; Yang, S.; Peng, L.; Pan, S. Active compound identification by screening 33 essential oil monomers against Botryosphaeria dothidea from postharvest kiwifruit and its potential action mode. Pestic. Biochem. Physiol. 2021, 179, 104957. [Google Scholar]
- Pan, H.; Zhong, C.; Xia, L.; Li, W.; Wang, Z.; Deng, L.; Li, L.; Long, C.A. Antifungal activity of natamycin against kiwifruit soft rot caused by Botryosphaeria dothidea and potential mechanisms. Sci. Hortic. 2022, 305, 111344. [Google Scholar]
- Huang, Y.; Sun, C.; Guan, X.; Lian, S.; Li, B.; Wang, C. Biocontrol efficiency of Meyerozyma guilliermondii Y-1 against apple postharvest decay caused by Botryosphaeria dothidea and the possible mechanisms of action. Int. J. Food. Microbiol. 2021, 338, 108957. [Google Scholar] [PubMed]
- Siroli, L.; Patrignani, F.; Serrazanetti, D.I.; Gardini, F.; Lanciotti, R. Innovative strategies based on the use of bio-control agents to improve the safety shelf-life and quality of minimally processed fruits and vegetables. Trends Food Sci. Technol. 2015, 46, 302–310. [Google Scholar]
- Fira, D.; Dimkić, I.; Berić, T.; Lozo, J.; Stanković, S. Biological control of plant pathogens by Bacillus species. J. Biotechnol. 2018, 285, 44–55. [Google Scholar] [CrossRef]
- Schisler, D.; Slininger, P.; Behle, R.; Jackson, M. Formulation of Bacillus spp., for biological control of plant diseases. Phytopathology 2004, 94, 1267–1271. [Google Scholar]
- Apaliya, M.T.; Zhang, H.; Zheng, X.; Yang, Q.; Mahunu, G.K.; Kwaw, E. Exogenous trehalose enhanced the biocontrol efficacy of Hanseniaspora uvarum against grape berry rots caused by Aspergillus tubingensis and Penicillium commune. J. Sci. Food Agric. 2018, 98, 4665–4672. [Google Scholar] [PubMed]
- Tejero, P.; Martín, A.; Rodríguez, A.; Galván, A.I.; Ruiz-Moyano, S.; Hernández, A. In vitro biological control of Aspergillus flavus by Hanseniaspora opuntiae L479 and Hanseniaspora uvarum L793 producers of antifungal volatile organic compounds. Toxins 2021, 13, 663. [Google Scholar] [CrossRef] [PubMed]
- Gómez-Albarrán, C.; Melguizo, C.; Patiño, B.; Vázquez, C.; Gil-Serna, J. Diversity of mycobiota in Spanish grape berries and selection of Hanseniaspora uvarum U1 to prevent mycotoxin contamination. Toxins 2021, 13, 649. [Google Scholar] [CrossRef] [PubMed]
- Wen, Q.; Liu, R.; He, T.; Zhang, W.; Chen, X. Identification of a new antifungal peptide W1 from a marine Bacillus amyloliquefaciens reveals its potential in controlling fungal plant diseases. Front. Microbiol. 2022, 13, 922454. [Google Scholar] [PubMed]
- Saravanakumar, D.; Thomas, A.; Banwarie, N. Antagonistic potential of lipopeptide producing Bacillus amyloliquefaciens against major vegetable pathogens. Eur. J. Plant. Pathol. 2019, 154, 319–335. [Google Scholar]
- Liu, Z.; Tian, J.; Yan, H.; Li, D.; Wang, X.; Liang, W.; Wang, G. Ethyl acetate produced by Hanseniaspora uvarum is a potential biocontrol agent against tomato fruit rot caused by Phytophthora nicotianae. Front. Microbiol. 2022, 13, 978920. [Google Scholar] [PubMed]
- Jamalizadeh, M.; Etebarian, H.; Aminian, H.; Alizadeh, A. A review of mechanisms of action of biological control organisms against post-harvest fruit spoilage. EPPO Bull. 2011, 41, 65–71. [Google Scholar] [CrossRef]
- Hamilton, A.; Holdom, M. Antioxidant systems in the pathogenic fungi of man and their role in virulence. Med. Mycol. 1999, 37, 375–389. [Google Scholar] [PubMed]
- Shi, H.; Zhou, X.; He, X.; Wang, R.; Zeng, E.L.; Zhou, W. Study on the antifungal mechanism of Chinese herbal extract on Botryosphaeria dothidea. J. Food. Process. Pres. 2022, 46, e16631. [Google Scholar]

| Number of Isolates | Accession Numbers of Reference Strain | Sequence Similarity (%) | Identified Species | Accession Numbers of Isolates |
|---|---|---|---|---|
| JNHT01 | MT177976.1 | 100.00 | Botryosphaeria dothidea | OP688105 |
| JNHT02 | MT177976.1 | 100.00 | Botryosphaeria dothidea | OP741034 |
| JNHT03 | MT177976.1 | 100.00 | Botryosphaeria dothidea | OP741050 |
| JNHT04 | OL614486.1 | 99.61 | Fusarium verticillioides | OP740381 |
| JNHT07 | ON329281.1 | 99.27 | Colletotrichum aenigma | OP740385 |
| JNHT08 | KP900277.1 | 99.44 | Colletotrichum gloeosporioides | OP740386 |
| JNHT09 | MW228103.1 | 99.26 | Colletotrichum siamense | OP740387 |
| Incubation Time (d) | Diameter of Disease Spot (cm) | Disease Index (%) | Incidence Rate (%) |
|---|---|---|---|
| 5 | 0.80 ± 0.25 | 22.22 ± 3.40 | 66.67 |
| 8 | 3.00 ± 0.24 | 72.22 ± 3.40 | 100 |
Publisher’s Note: MDPI stays neutral with regard to jurisdictional claims in published maps and institutional affiliations. |
© 2022 by the authors. Licensee MDPI, Basel, Switzerland. This article is an open access article distributed under the terms and conditions of the Creative Commons Attribution (CC BY) license (https://creativecommons.org/licenses/by/4.0/).
Share and Cite
Zhang, Q.Q.; Shi, J.; Shen, P.Y.; Xi, F.; Qian, C.Y.; Zhang, G.H.; Zhu, H.J.; Xiao, H.M. Exploring the Efficacy of Biocontrol Microbes against the Fungal Pathogen Botryosphaeria dothidea JNHT01 Isolated from Fresh Walnut Fruit. Foods 2022, 11, 3651. https://doi.org/10.3390/foods11223651
Zhang QQ, Shi J, Shen PY, Xi F, Qian CY, Zhang GH, Zhu HJ, Xiao HM. Exploring the Efficacy of Biocontrol Microbes against the Fungal Pathogen Botryosphaeria dothidea JNHT01 Isolated from Fresh Walnut Fruit. Foods. 2022; 11(22):3651. https://doi.org/10.3390/foods11223651
Chicago/Turabian StyleZhang, Qiu Qin, Jie Shi, Pei Yao Shen, Fei Xi, Cheng Yu Qian, Guo Hua Zhang, Hai Jun Zhu, and Hong Mei Xiao. 2022. "Exploring the Efficacy of Biocontrol Microbes against the Fungal Pathogen Botryosphaeria dothidea JNHT01 Isolated from Fresh Walnut Fruit" Foods 11, no. 22: 3651. https://doi.org/10.3390/foods11223651
APA StyleZhang, Q. Q., Shi, J., Shen, P. Y., Xi, F., Qian, C. Y., Zhang, G. H., Zhu, H. J., & Xiao, H. M. (2022). Exploring the Efficacy of Biocontrol Microbes against the Fungal Pathogen Botryosphaeria dothidea JNHT01 Isolated from Fresh Walnut Fruit. Foods, 11(22), 3651. https://doi.org/10.3390/foods11223651
